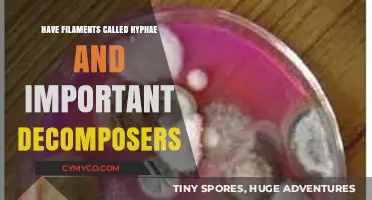
Fungal Filaments: The Hyphae's Role in Nature's Decomposition Process

The topic have hypha with a clamp connection appears to be a specific technical or scientific subject, potentially related to biology, mycology, or a similar field. To introduce this topic, one might say:
In the study of fungi, particularly in mycology, the term 'hypha' refers to the branching, thread-like structures that form the main body of a fungus. These hyphae can sometimes form specialized structures known as 'clamp connections,' which are crucial for the growth and development of certain fungal species. Clamp connections are ring-like structures that encircle the hypha, allowing for the passage of nutrients and genetic material between different parts of the fungal network. Understanding the formation and function of these clamp connections is essential for researchers studying fungal biology, as they play a significant role in the overall health and behavior of fungal organisms.
This introduction provides a clear and concise overview of the topic, explaining the key concepts and their relevance in the field of mycology.
Explore related products
What You'll Learn
- Types of Clamp Connectors: Explore various clamp designs used in hyphenated compound connections
- Installation Techniques: Discuss methods for securely attaching hyphens to clamps in different materials
- Material Compatibility: Examine which materials work best with clamp connections in hyphenated compounds
- Strength and Durability: Analyze the mechanical properties of hyphen-clamp connections under stress
- Applications in Industries: Identify industries where hyphenated compounds with clamp connections are commonly used

Types of Clamp Connectors: Explore various clamp designs used in hyphenated compound connections
Clamp connectors are essential components in creating hyphenated compound connections, offering a secure and reliable means of joining two separate entities. One common type of clamp connector is the hose clamp, which utilizes a worm drive mechanism to tighten a band around the hose, ensuring a leak-proof seal. This design is particularly effective for applications involving fluid or gas transfer, where maintaining pressure and preventing contamination are critical.
Another variation is the bar clamp, which features a horizontal bar that is tightened or loosened using a screw mechanism. Bar clamps are often used in woodworking and metalworking projects, where they can hold pieces together firmly during gluing or welding processes. The simplicity of their design makes them easy to use and adjust, even in tight spaces.
For more specialized applications, there are clamp connectors with integrated sensors or valves. These smart clamps can monitor and control the flow of materials through the connection, providing real-time data and feedback to operators. Such advanced designs are particularly valuable in industrial settings, where precise control and monitoring are essential for efficiency and safety.
When selecting a clamp connector for a hyphenated compound connection, it is important to consider factors such as the materials being joined, the environmental conditions, and the required level of security. By choosing the appropriate clamp design, one can ensure a strong and durable connection that meets the specific needs of the application.
Are Hyphae Apparent on Course Hero? Exploring Fungal Networks in Learning
You may want to see also
Explore related products

Installation Techniques: Discuss methods for securely attaching hyphens to clamps in different materials
When installing hyphens with clamp connections, it's crucial to ensure they are securely attached to prevent any potential hazards or malfunctions. One effective method is to use a combination of mechanical and adhesive techniques. First, position the hyphen accurately within the clamp, ensuring it is centered and aligned with the desired orientation. Next, apply a suitable adhesive to the contact surfaces of both the hyphen and the clamp. This will provide an initial bond that can be reinforced through mechanical means.
For added security, consider using screws or bolts to fasten the hyphen to the clamp. This approach is particularly useful when working with materials that may not hold adhesive well, such as certain plastics or metals. Drill pilot holes through the hyphen and clamp, ensuring they are properly aligned, and then insert the fasteners. Tighten them gradually, being careful not to overtighten, which could damage the materials or loosen the connection.
In cases where the hyphen and clamp are made of dissimilar materials, it may be necessary to use specialized fasteners or adapters to ensure compatibility. For example, when connecting a metal hyphen to a plastic clamp, using a metal-to-plastic adapter can help distribute the load more evenly and prevent damage to the plastic. Additionally, consider using washers or spacers to provide extra support and reduce the risk of the connection coming loose over time.
Another important factor to consider is the environmental conditions in which the hyphen and clamp will be used. If they will be exposed to moisture, chemicals, or extreme temperatures, it's essential to choose materials and adhesives that are resistant to these conditions. This may involve using stainless steel or other corrosion-resistant metals for the hyphen, and selecting adhesives that are specifically designed for use in harsh environments.
Finally, always follow the manufacturer's instructions for both the hyphen and the clamp, as well as any relevant industry standards or regulations. This will help ensure that the installation is done safely and effectively, and that the hyphen and clamp will perform as intended. Regularly inspect the connection to ensure it remains secure, and make any necessary adjustments or replacements as needed.
Exploring the Hyphal Structure of Deuteromycota: A Comprehensive Overview
You may want to see also
Explore related products

Material Compatibility: Examine which materials work best with clamp connections in hyphenated compounds
When selecting materials for clamp connections in hyphenated compounds, it is crucial to consider the chemical compatibility between the clamp material and the compounds involved. For instance, stainless steel clamps are often preferred due to their resistance to corrosion and ability to withstand harsh chemicals. However, in certain cases, such as when dealing with highly reactive compounds, specialized materials like titanium or Hastelloy may be necessary to prevent unwanted reactions.
Another important factor to consider is the physical properties of the materials. The clamp must be able to exert sufficient pressure to create a secure connection without damaging the compound or the equipment. This requires a balance between strength and flexibility. Materials like aluminum or copper may be too soft for certain applications, while materials like tungsten carbide may be too brittle.
In addition to chemical and physical compatibility, it is also essential to consider the temperature and pressure conditions under which the clamp connection will be used. Some materials may degrade or become brittle at high temperatures, while others may not be able to withstand the pressure required for a secure connection. For example, when working with volatile compounds, it may be necessary to use materials that can maintain their integrity at low temperatures and high pressures.
When evaluating material compatibility, it is important to consult industry standards and guidelines, as well as manufacturer recommendations. This can help ensure that the chosen material is suitable for the specific application and will not compromise the safety or efficiency of the process. Additionally, it may be beneficial to conduct testing or trials to verify the performance of the material under the intended conditions.
In conclusion, selecting the right material for clamp connections in hyphenated compounds requires careful consideration of chemical compatibility, physical properties, and operating conditions. By taking these factors into account and consulting relevant resources, it is possible to choose a material that will provide a secure and reliable connection while minimizing the risk of damage or failure.
Exploring the Hyphal Structure of Deuteromycota: A Comprehensive Guide
You may want to see also
Explore related products
$22.32 $23.59

Strength and Durability: Analyze the mechanical properties of hyphen-clamp connections under stress
The mechanical properties of hyphen-clamp connections are crucial in determining their suitability for various applications. Under stress, these connections must exhibit sufficient strength and durability to ensure the integrity of the structure they are part of. A detailed analysis involves examining the materials used, the design of the clamp, and the nature of the stress applied.
Materials play a significant role in the strength of hyphen-clamp connections. Common materials include stainless steel, aluminum, and various alloys, each with its own tensile strength and resistance to corrosion. The choice of material depends on the specific requirements of the application, such as the need for high strength, resistance to environmental factors, or ease of installation.
The design of the clamp is another critical factor. Clamps must be engineered to distribute stress evenly across the connection, minimizing the risk of failure at any single point. This involves careful consideration of the clamp's geometry, the type of fastening mechanism used, and the method of attachment to the hyphen.
Stress analysis is essential to understand how the connection will perform under different conditions. This includes evaluating the connection's ability to withstand tensile, compressive, and shear forces, as well as its resistance to fatigue and creep. Finite element analysis (FEA) is often used to simulate these conditions and predict the behavior of the connection under stress.
In addition to material and design considerations, the installation process also affects the strength and durability of hyphen-clamp connections. Proper installation ensures that the connection is secure and that the stress is distributed as intended by the design. This may involve specific techniques or tools to achieve the desired level of tightness and alignment.
Overall, the analysis of hyphen-clamp connections under stress requires a comprehensive approach that considers materials, design, stress conditions, and installation techniques. By understanding these factors, engineers can design connections that are both strong and durable, ensuring the safety and reliability of the structures they support.
Exploring the Fascinating World of Penicillium: Septate Hyphae and Beyond
You may want to see also
Explore related products

Applications in Industries: Identify industries where hyphenated compounds with clamp connections are commonly used
The construction industry is one of the primary sectors where hyphenated compounds with clamp connections are extensively utilized. These compounds, often referred to as "clamp connectors," play a crucial role in joining structural elements such as beams, columns, and trusses. The use of clamp connectors allows for efficient assembly and disassembly, making them ideal for both permanent and temporary structures. Additionally, their ability to provide strong, reliable connections without the need for welding or drilling makes them a preferred choice in many construction projects.
In the realm of manufacturing, hyphenated compounds with clamp connections are commonly used in the assembly of machinery and equipment. These connectors enable the quick and secure attachment of various components, facilitating the production process and reducing downtime. Furthermore, their versatility allows for easy customization and adaptation to different types of machinery, making them a valuable tool in the manufacturing industry.
The automotive industry also benefits from the use of hyphenated compounds with clamp connections. These connectors are often employed in the assembly of vehicle frames, suspension systems, and other critical components. Their ability to provide strong, durable connections while allowing for easy maintenance and repair makes them an essential part of modern automotive design.
In the field of aerospace engineering, hyphenated compounds with clamp connections are used in the construction of aircraft and spacecraft. These connectors are particularly valuable in aerospace applications due to their ability to withstand extreme temperatures and pressures while maintaining a secure connection. Additionally, their lightweight nature contributes to the overall efficiency and performance of aerospace vehicles.
Finally, the marine industry utilizes hyphenated compounds with clamp connections in the construction of ships and boats. These connectors are well-suited for marine applications due to their resistance to corrosion and their ability to provide strong, reliable connections in a harsh environment. From hull construction to the assembly of deck structures, clamp connectors play a vital role in the marine industry.
Exploring the Fascinating World of Yeast Coenocytic Hyphae
You may want to see also
Frequently asked questions
A hypha is a long, branching filamentous structure of a fungus, oomycete, or cyanobacterium. It is the basic unit of these organisms and is responsible for growth and nutrient absorption.
A clamp connection is a specialized structure in certain fungi that connects adjacent hyphae. It is a ring-like formation that encircles one hypha and attaches to another, allowing for the transfer of nutrients and communication between the hyphae.
Hyphae with clamp connections contribute to the growth of fungi by facilitating the efficient transfer of nutrients and signaling molecules between different parts of the fungal network. This interconnected system allows for coordinated growth and adaptation to environmental conditions.
No, clamp connections are not found in all types of fungi. They are primarily associated with the Basidiomycota and Ascomycota phyla, which include many common fungal species such as mushrooms and yeasts.
The advantages of having hyphae with clamp connections in a fungal organism include enhanced nutrient uptake, improved communication between different parts of the organism, and increased resistance to environmental stressors. These connections allow for a more efficient and coordinated functioning of the fungal network, contributing to its overall survival and success.